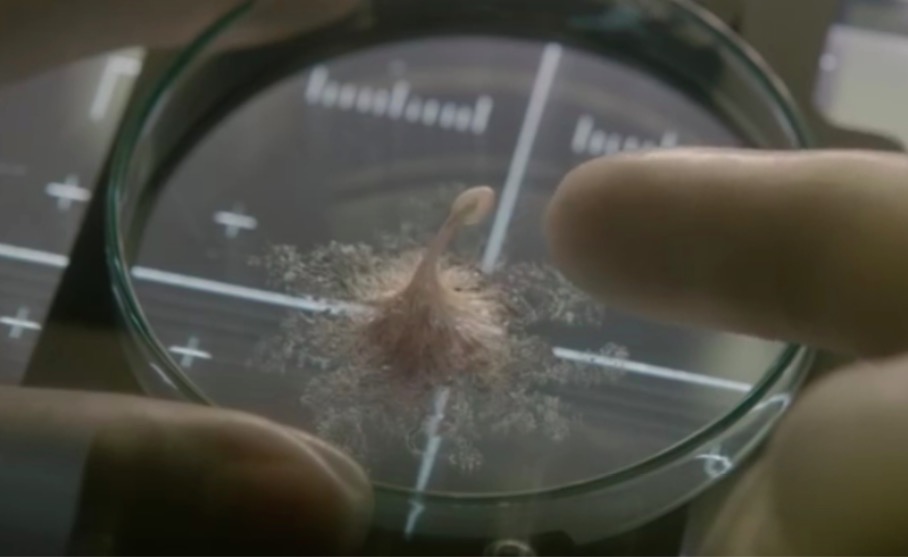

Ciel & Espace
L’astronautique est une science qui paraît n’avoir aucune limite. L’envoi de vaisseaux dans l’espace, habités ou non, au-delà de l’atmosphère terrestre le prouve chaque jour. Les objectifs de l’astronautique sont nombreux : améliorer le rendement des systèmes de production thermique, d’énergie et de protection contre les radiations, accroître les performances des télécommunications, développer des systèmes de navigation performants… L’ingénierie spatiale a de nombreuses cordes à son arc !
Au-delà de la science, le ciel a de tout temps été l’objet de rêves, de croyances ou d’appréhensions, amenant l’homme à se dépasser, à rêver ou à craindre les répercussions d’un espace qui le dépasse…
Suivez dans cette rubrique, toute l’actualité spatiale et les derniers événements astronomiques !